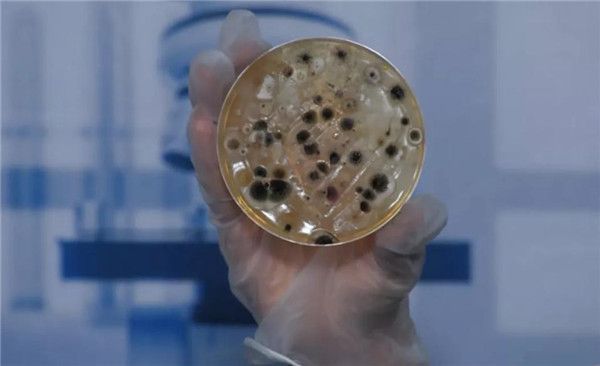

揭秘家中细菌真面目,排名第一的竟然是它!
忙碌的生活中最期待的应该就是回到家的那一刻,感觉整个心灵都有了归属地,冲个热水澡,再来个葛优躺,家中的生活就是这么的舒适。可以你知道吗?就在你认为最放松的空间里,其实各种藏污纳垢,客厅、厨房、卧室、卫生间化身细菌聚集地,时刻威胁着你和家人的生活健康。家中细菌有多少?为了让更多小伙伴了解家中细菌滋生情况,小编特意总结了一些病菌最喜欢聚集的地点,赶紧来了解一下吧~

家中最脏的五点请务必注意
首先咱们先来盘点一下家中最容易聚集细菌的五个地方,在日常生活中一定要注意清洁。

毛巾、枕头这些看起来比较柔软的物品,确实细菌、尘螨滋生的天堂,肉眼可见的大菌斑以及零零星星的其它细菌经常在上面活跃。

厨房案板是厨房不可或缺的工具,许多食材在入口前都会与其来一次“亲密接触”,因此凹凸不平的刀痕里充满食物残渣,再加上经常置于阴暗潮湿的环境中,细菌很容易滋生。

家中养宠物的朋友们要注意,据统计2周未清洗的猫砂盆,细菌数量多达10万个。

居家实木地板的缝隙中富含有机物而且温暖潮湿,使其很容易成为有害微生物滋生的温床。
神秘X地点 竟是细菌重灾区
聊完家居细菌量最大的五个地方,咱们再说一处神秘地点的细菌。以上图片是我们在神秘X地点采集到的细菌,可以看到的是相较于前几处的细菌,神秘地点的细菌菌斑大、颜色黑、分布密集、细菌量也最多。那么它究竟是什么地方呢?其实这处细菌重灾区就是空调内部。
据悉居家环境中,灰尘、细菌会随着空气在房间内流动,空调在换气过程中,灰尘和细菌会进入空调内部,沉积其中。空调内部久不清洗,堆积的污染物也就越来越多,所以我们才会看到空调内部取样点有大量细菌滋生。
智能双净化守护清洁家
看完以上对于空调内部细菌的解读,你是否感叹于细菌的无处不在、无孔不入呢?那么有没有什么办法可以有效的抑制细菌滋生,净化室内的空气呢?或许日立中央空调新生态室内净化机能给我们的家居生活注入新鲜的活力,空调自清洁+空调净化,由内而外的保证室内空气洁净。
日立中央空调新生态室内机搭载的PE纯净生态模块,其释放的负离子可以破坏细菌细胞结构,杀灭细菌病毒且不存在有害物质残留。据广东省微生物分析检测中心数据显示,PE纯净生态模块对H3N2流感病毒的去除率可达96.85%,大肠杆菌去除率可达96.64%,金黄色葡萄球菌去除率可达93.88%。

除细菌、霉菌外,新生态室内机还可去除居家生活常见的甲醛、PM2.5、异味、尘螨等污染物,全面解决室内空气污染。且日立中央空调还可“自己洗澡”,进行空调内部自清洁,通过预处理-结霜-清洁-烘干四步,自动清洁空调换热器上的污渍,避免普通空调内部细菌灰尘沉积的情况发生,从源头保证松风清洁。
家,是我们身体与情感的归宿,一个舒适、洁净、安心的家才能给予每个人幸福的体验和足够的安全感。日立中央空调智能双净化,室内自清洁+空气净化,双重呵护双重保障,为你和家人打造健康洁净的生态家。
文中部分图片源自网络:侵删
免责声明
此文内容为企业宣传资讯,仅代表作者个人观点,与本网无关。仅供读者参考,并请自行核实相关内容。如果您发现网站上有侵犯您的知识产权的作品,请与我们取得联系,邮箱:3528360990@qq.com ,我们会及时修改或删除。
网址:揭秘家中细菌真面目,排名第一的竟然是它! https://c.jiaju82.com/news-view-id-700708.html

